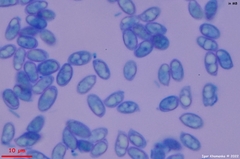
Lepista graveolens

Lepista graveolens: taxon details and analytics
- Domain
- Kingdom
- Fungi
- Phylum
- Basidiomycota
- Class
- Agaricomycetes
- Order
- Agaricales
- Family
- Clitocybaceae
- Genus
- Lepista
- Species
- Lepista graveolens
- Scientific Name
- Lepista graveolens
Lepista graveolens in languages:
- Czech
- čirůvka těžká
- Estonian
- haisev ebaheinik
Images from inaturalist.org observations:
We recommend you sign up for this excellent, free service.
Parent Taxon
Sibling Taxa
- Lepista argentina
- Lepista caespitosa
- Lepista caffrorum
- Lepista densifolia
- Lepista fibrosissima
- Lepista glabella
- Lepista glaucocana
- Lepista graveolens
- Lepista irina
- Lepista irinoides
- Lepista luscina
- Lepista multiformis
- Lepista nimbata
- Lepista nuda
- Lepista ovispora
- Lepista personata
- Lepista ricekii
- Lepista rickenii
- Lepista semiochracea
- Lepista sordida
- Lepista subaequalis
- Lepista subalpina
- Lepista subconnexa
- Lepista subisabellina
- Lepista sublilacina
- Lepista tarda
- Lepista tomentosa